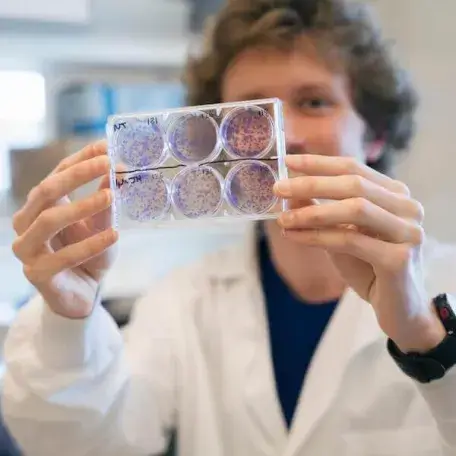

UVM News brings you the University of Vermont’s top stories, showcasing breakthrough research, timely solutions and experts, and news from Vermont’s flagship university.
Featured News

With Bright Sun and Bold Advice, UVM Celebrates Graduates at Commencement 2026

New Economics Study Finds ICE Activity Upended the U.S. Childcare Workforce

Record Number of 14 UVM Student Fulbright Winners are Announced, Ready to Exchange Knowledge and Skills Across the Globe

Meet the Class of 2026

Jihong Ma Receives NSF CAREER Award for Quantum-Inspired Vibration Control Research